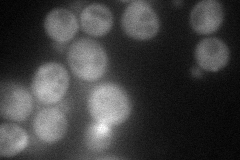
YGR221C
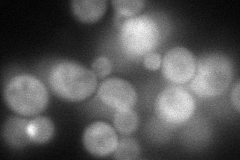
YGR221C
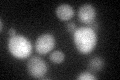
YGR221C

View description
Protein involved in localization of Cdc24p to the site of bud growth; may act as a membrane anchor; localizes to the bud neck and bud tip; potentially phosphorylated by Cdc28p
Localization:
Intensity:
Fold change:
Significance:
-
C’ GFP library in SD

below threshold15.36 -
N' NOP1pr-GFP in SD
cytosol,bud52.619 -
N' TEF2pr-mCherry in SD
bud76.5995 -
N' NATIVEpr-GFP in SD

bud20.684 -
N' TEF2pr-VC and Cyto-VN in SD

cytosol37.2504 -
C’ GFP library in SD+DTT
cytosol16.521.07No -
C’ GFP library in SD+H2O2

cytosol18.881.22No -
C’ GFP library in Starvation Media

cytosol17.841.16No -
C’ GFP library on the background of Pup2-DaMP

below threshold -
C’ GFP library on the background of CCT mutant

below threshold17.00921.10701No
